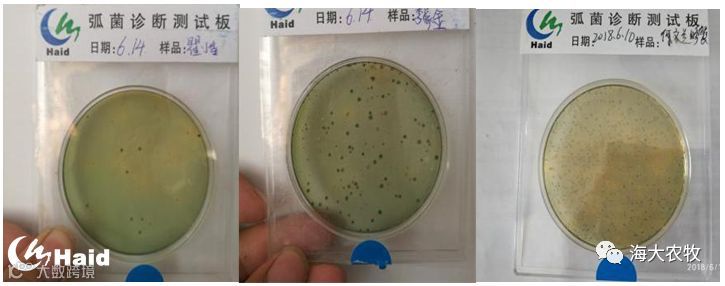

文 | 图 动保事业部 汪帆
监利的虾蟹混养模式是监利县棋盘镇非常主流的一种养殖模式,然而这种模式每年的这段时间,一开始死虾,到后来死虾又死螃蟹,根本原因是什么?
1. 天气
很多塘口最近的死亡量都非常大,根据过往经验,过了小暑之后龙虾的死亡量才会逐渐减少,其实最近正处于入梅阶段——6月13日~7月14日,梅雨季节最典型的特点就是气温波动大,晴雨交替带来的气温和气压波动,最容易造成池塘返底现象,底部泥水交界面被打破,造成有害物质释放进入底部水体,造成底部的严重缺氧。

图1. 变天缺氧虾子上草
2. 密度
虾蟹混养最难判断的就是龙虾的密度,龙虾密度大也是大量死虾最关键的因素。
龙虾密度过高的三大危害:
一、龙虾之间的相互残食,造成弧菌的交叉感染;

图2. 被残食的龙虾
二、水草难保,后期螃蟹的产量也无法保障;
三、投喂量也就相对越大,残饵粪便也就越多,造成了水质、底质的破坏。
很多老板明明知道密度易造成大量死虾,但就是舍不得卖虾,总担心后期价高时没有虾子卖,宁可天天捞死虾也不愿意下笼去卖虾,殊不知龙虾密度大除了死虾以外,也容易造成螃蟹的死亡,更容易造成环境的破坏,影响后期螃蟹的养殖。
因此,如何判断池塘中龙虾的密度是非常关键的环节。单纯的通过起捕判断密度是不准确的,很多老板施不到虾,觉得虾子密度不大,其实很多池塘只是大规格的虾不多,梯度苗还是很多的;判断密度的方式主要有三种——投喂量、起虾和上草情况。通过起虾和上草情况判断整个池塘中是否有梯度苗,再结合投喂量综合分析池塘中的密度大小。
密度较大的池塘要趁早卖虾!
表1. 密度较大客户卖虾与死虾情况

由表1.可看出,密度较大的客户,累计卖虾越多的客户,近期死亡量逐渐减少,死虾总量也相对较低,除了朱老板亩起捕量达到133斤/亩,死虾量依然很大,主要原因是很早就开始投喂冰鲜与环境遭到了破坏(水草几乎泡掉)。
3. 投喂
正确的投喂方式对于死虾的控制有着关键的影响。发病期到底是投喂饲料、冰鱼、黄豆还是小麦?

发病期黄豆和冰鱼是坚决不能投喂的,因为黄豆的高植物蛋白会给虾蟹的肝胰腺带来严重的负荷,而冰鱼不仅带有大量致病菌(见图4),吃了以后易得肠炎,而且大量的投喂冰鲜易坏水,蓝藻会提前爆发。

图3. 冰鱼所携带的弧菌
发病期:
1. 投喂以饲料为主,可以适当添加煮熟的小麦(煮熟后更易消化),可根据具体情况适当的控料,不能不投喂,龙虾相互残食,极易造成弧菌的交叉感染(见图5)。
2. 发病期可使用虾多宝干拌,一包虾多宝拌4包饲料增加诱食性,拌3天停3天,直到死虾开始好转,让体质好的虾能吃下饲料。
图4. 病虾、病蟹体内的弧菌

图5. 虾多宝干拌
4. 环境
入梅期最担心就是水草泡头、活力下降和底质差。水草泡头、活力下降,失去净水能力,产氧能力减弱;此时底质越差,变天时底部耗氧严重,造成缺氧浮头。
4.1 水草泡头、活力下降

图6. 水草泡头
表1. 水草调研情况


图7. 水草覆盖面积与泡草比例的关系
从表中不难看出,前期水草种的越厚,泡草的比例就会高出很多,主要原因是水草过密,中间的水草接触不到光照,并且影响水流流通,底部极易烂。
A. 泡草处理:赶在高温之前赶紧处理
1. 泡草比例较高的池塘,疏沟插竹竿,这种池塘一旦大面积疏草,大风天易把水草卷成一团,更易坏水;
2. 泡草比例较低的池塘,少量多次的捞出泡草(避免因疏草导致底部营养释放造成蓝藻爆发);

图8. 正确的水草管理
3. 环沟水草尽量留出间隙,烂草及时清理,避免地笼附近缺氧,进笼死虾。
B. 预防泡草:
1. 晚种草(放蟹苗前15~20天左右),以防前期长势过猛;
2. 控水位,水加的越深,水草向上长的越凶,抓地力越差;
3. 种草间距保证5~8米一株,留出足够的间隙,便于水流流动和光照照射;
4. 疏草要趁早、各个击破,4月长势过猛时就要疏草打头,少量多次的疏草;
5. 少量多次用肥提升水草活力,建议1包藻源素+2包3101用15亩面积,晴天上午混合化水泼洒;

图9. 保草套餐
6. 龙虾密度较高时,及时卖虾。
4.2 底质差
池塘的底部相当于大型的垃圾场,池塘中所有的代谢废物都沉积到底部,一旦变天返底,极其容易造成底部严重缺氧。因此,不仅要定期改底,还要早改底。


底泥的ORP能够反映底泥的好坏程度,ORP越低底泥越差,虾蟹池塘的ORP低于 - 130就要注意改底了,从调查结果可知大部分虾蟹混养客户不太重视底质,等出了问题才想到要改底。
建议:定期改善底部环境,晴天上午使用底倍健,1包底倍健用4亩面积。(变天提前改底预防有效预防上草)
5. 小结
死虾不要慌,用药只是一方面,管理非常重要。
1、投喂:停喂冰鱼和黄豆,以饲料为主,适当控料,虾多宝拌料增加诱食性;
2、正确的水草管理,赶在高温前处理,保住水草,以防烂草坏水;
3、及时卖虾,降低龙虾密度;
4、定期使用底倍健改底,改善底部环境。
补钙和不补钙,对小龙虾差异有多大?实验还原的真相,超乎你想象!


